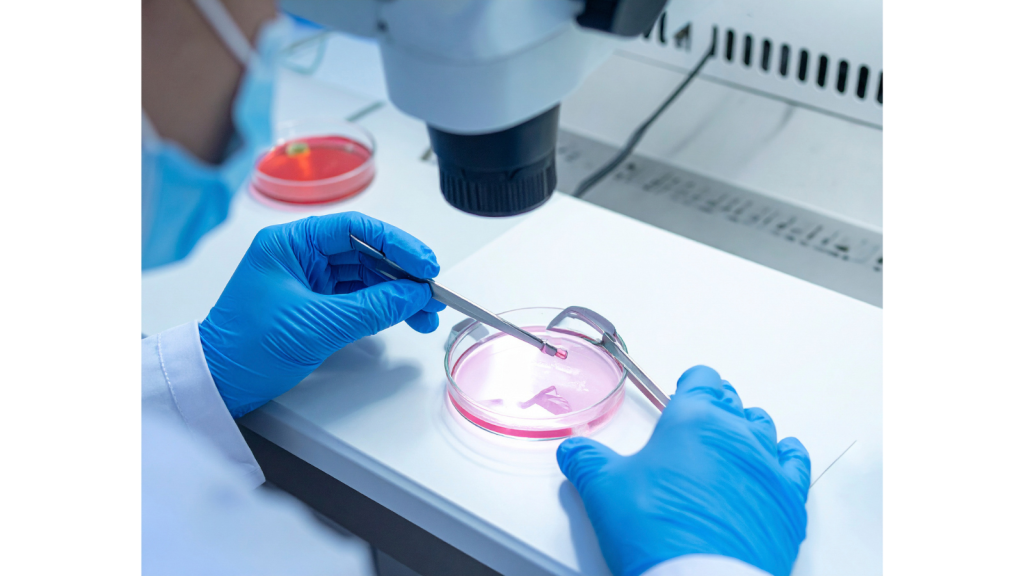

EL COSTO DEL COPAGO LIBRE ELECCIÓN ADEMÁS ASCIENDE A MÁS DE $2 MILLONES
Fertilización asistida con Fonasa: disponible en solo cinco regiones y con años de espera
26.02.2026
Hoy nuestra principal fuente de financiamiento son nuestros socios. ¡ÚNETE a la Comunidad +CIPER!
EL COSTO DEL COPAGO LIBRE ELECCIÓN ADEMÁS ASCIENDE A MÁS DE $2 MILLONES
26.02.2026
La Organización Mundial de la Salud (OMS) estima que una de cada seis personas en edad reproductiva es infértil. Para esta investigación se recogieron los testimonios de 66 mujeres que han estado en tratamiento por esta enfermedad en el sistema público chileno. Aquellas pacientes en modalidad de copago cero esperaron en promedio dos años y siete meses desde el diagnóstico hasta que fueron atendidas. El resto optó por comprar un bono de Fonasa para acceder a establecimientos privados. Pero esa no es una opción para todas: los prestadores adheridos sólo se encuentran en cinco regiones del país, el costo del copago supera los $2 millones y la espera promedio para ser atendida es de un año y siete meses.
Collage: Isidora Prieto
En enero de 2022, Jessica Durán (42), en ese entonces de 39 años, decidió que era momento de que su hijo de 4 años, Dylan, tuviera un hermano. Sabía que, dada su edad, el proceso podría ser más complicado que en su primer embarazo, por lo que acudió a IntegraMédica para realizarse exámenes y evaluar la posibilidad de un eventual tratamiento de fertilización asistida. Se llama así al conjunto de técnicas médicas que ayudan a las personas a embarazarse cuando no pueden lograrlo de manera natural.
Al ver los resultados de Jessica, el doctor le dijo que tenía que volver en unos cuatro o cinco meses más porque todavía tenía las “hormonas revoloteadas” por el uso de anticonceptivos, dice Durán, quien también cuenta que se sintió pasada a llevar por la frialdad del médico.
Al igual que muchas mujeres, durante todo el proceso Jessica fue tratada en el sistema público de salud en la Modalidad de Libre Elección (MLE), la cual permite a los usuarios decidir dónde atenderse e incluso hacerlo en algunas entidades privadas. Esto se hace a través de los Bonos de Pago Asociado a Diagnóstico (PAD), que cubren el 50% de los tratamientos y donde los cupos los establece cada centro de salud. La otra opción es la Modalidad de Atención Institucional (MAI), que ofrece copago cero y una cantidad limitada de cupos anuales para tratamientos de fertilidad asistida.

Pese a las facilidades económicas que se dan, según el especialista en reproducción asistida y cofundador del Instituto Chileno de Medicina Reproductiva (ICMER), el doctor Fernando Zegers, seguimos estando al debe: “En Chile se hacen alrededor de 10.500 ciclos de reproducción asistida al año (…) cuando deberíamos estar haciendo aproximadamente 20.000 para cubrir las necesidades del país”.
Jessica, haciendo uso de este bono y luego de haber dejado pasar los meses recomendados por el doctor, decidió cambiar de establecimiento. Así, en agosto de 2022 fue a atenderse al Hospital del Profesor, ubicado en Estación Central, uno de los seis que ofrecen procedimientos de fertilización asistida a través de Bono PAD en la Región Metropolitana, aunque sólo para tratamientos de baja complejidad, es decir, de inseminación artificial.
Al llegar a su cita con el especialista en fertilidad, le comunicaron que el doctor no iba a poder llegar. Fue ahí cuando, según relata Jessica, comenzó la desmotivación y la angustia. Sus amistades le decían que estuviera tranquila, que con tiempo y paciencia iba a quedar embarazada. Sin embargo, ella sabía que lo que menos tenía era tiempo; ya casi rondaba los 40 años.
Dejó pasar unos meses para prepararse de manera óptima y “limpiar su cuerpo” de las hormonas que le impedían conseguir un embarazo, según lo que le habían dicho en IntegraMédica. Acudió al Centro de Salud Familiar San José de Chuchunco en la Región Metropolitana en donde, nuevamente, le hicieron varios exámenes. Ahí le informaron que la iban a derivar al Instituto de Investigación Materno Infantil (IDIMI) del Hospital Clínico de la Universidad de Chile, el cual también está dentro de las coberturas por Bonos PAD.
En todo ese tiempo, jamás le dieron a conocer a Jessica su puesto en la lista de espera: “Iba al consultorio todos los meses a joder: ‘Ya pues, ¿cuándo me van a llamar de IDIMI?’, les decía. Ellos me respondían que tenía que esperar nomás, que no me preocupara, pero ya llevaba más de un año esperando a que me derivaran”, cuenta. Gracias a distintos testimonios pudimos recabar que Jessica no era la única a la que le pasaba esto, ya que quienes buscan acceder a los procedimientos no reciben información sobre la lista de espera: no saben en qué lugar se encuentran ni con qué rapidez avanza.
Con el paso de los meses y ante la falta de respuestas, decidió actuar por cuenta propia dejando de lado los protocolos del hospital. Fue así como en mayo de 2023 llegó al Hospital Clínico de la Universidad de Chile para hacerse el examen antimulleriano, el cual indica el estado de la reserva ovárica, es decir, la cantidad de óvulos que tiene una mujer en sus ovarios.
El diagnóstico de Jessica arrojó 0,02 de hormona antimulleriana (AMH) —proteína que refleja la cantidad de óvulos disponibles— cuando el rango deseable de AMH es de 1 a 2,9. Durán presentaba una cantidad muy baja para poder embarazarse: “El doctor vio mi resultado y dijo que con ese diagnóstico sería imposible tener un hijo. Que en sus 45 años de trabajo en el hospital nunca había visto a alguien salir embarazada con ese número de antimulleriana. En fin, yo lloré a mar de lágrimas”, recuerda apenada.

Créditos: CIPER
Pese a la tristeza, Jessica no se rindió y buscó una segunda opinión en la clínica de fertilidad CER, ubicada en la comuna de Las Condes, y en julio de 2023, por fin pudo comenzar sus tratamientos. Le propusieron que fueran de menos a más, es decir, empezar con el procedimiento de baja complejidad para eventualmente pasar a los de alta. Comenzó con una inseminación artificial que resultó fallida, posteriormente se realizó una fertilización in vitro que terminó en pérdida y luego se hizo otra transferencia, pero con ovodonación, es decir, con un óvulo donado por otra mujer, que tampoco tuvo éxito. Finalmente, y ya determinada a rendirse si es que no daba resultado, el 16 de abril de 2025, le realizaron una segunda transferencia de ovodonación. Esta vez, el resultado fue positivo.
Jessica Durán estuvo al borde de perder la batalla contra el tiempo. Las negligencias médicas —como el concepto de “hormonas revoloteadas” a causa de anticonceptivos— y los tiempos de espera por una derivación hicieron que el proceso no sólo se tornara tedioso, sino que también largo. Actualmente, y por sobre cualquier estadística, a sus 42 años Jessica sostiene en sus brazos a su hija Milagros; nombre que no es casualidad, sino reflejo del largo camino que recorrió para tenerla.
Cuando el reloj biológico te va alcanzando, el tiempo de espera para recibir tratamientos de fertilidad asistida se convierte en un factor sumamente relevante: cada minuto cuenta porque cada óvulo cuenta. El doctor Zegers explica que los embarazos luego de los 35 años pueden llegar a ser un problema porque los óvulos van disminuyendo con los años y al llegar a esa edad la baja es más drástica. Por otro lado, con el pasar del tiempo, los óvulos van presentando cada vez más errores cromosómicos: “Esas dos cosas juntas hacen que la mujer sea muy poco eficiente reproductivamente”, comenta.
Fiorella Squadritto, creadora de la Fundación Fënn —organización dedicada a apoyar a personas infértiles, educar sobre el tema y promover la investigación y el desarrollo de políticas públicas— comenta que la situación de las listas de espera es una preocupación constante entre las mujeres con las que trabajan. “Lo más angustioso de estar en esta lista de espera es que no hay visibilidad (…), no se sabe cuánto se demora”. Según su relato, quienes esperan no tienen cómo prepararse adecuadamente para el momento en que les llegue su turno, porque eso puede ocurrir en un par de semanas o varios meses más.
A través de la Ley de Transparencia, se ingresó una solicitud de acceso a la información pública a Fonasa. En esta, se pidió el número de personas en lista de espera, su tiempo aproximado y los hospitales en que se realizan los respectivos tratamientos de fertilización asistida desde el 1 de enero de 2023 hasta abril de 2025. Esta fue derivada a la Subsecretaría de Redes Asistenciales la cual respondió que “en la lista de espera no hay codificación diagnóstica estandarizada para una búsqueda exacta, asimismo, en la especialidad ‘07-072 Medicina Reproductiva E Infertilidad’ no se encuentran datos disponibles registrados a nivel institucional, por lo anteriormente expuesto, no es posible entregar la información”.
Al igual que nuestro equipo, Fiorella ha solicitado la información de las listas de espera a través de la Ley de Transparencia y los resultados han sido los siguientes: “Pedí [la información] primero a Fonasa, de Fonasa me mandaron a la Superintendencia de Salud, después de la Superintendencia me mandaron al Minsal. Y así te van pimponeando, sobre todo cuando se trata de la Modalidad de Atención Institucional”, comenta la creadora de Fënn. Esta situación, sin duda, activa las alarmas sobre el manejo de información que tiene el sistema público respecto a la espera para recibir un tratamiento de fertilización asistida.
Consultados al respecto, en Fonasa señalan que no hay una lista de espera para estos tratamientos, sino que solo hay una cantidad de cupos específicos que se van utilizando durante el año.
Dada la falta de información respecto al tema, se realizó un Google Forms difundido por grupos de Instagram y Facebook —como “Fertilidad Chile: Buscando un hij@”— y a través de las redes sociales de líderes de opinión en la materia, quienes fomentaron las respuestas del mismo. Esto nos ayudó a encontrar testimonios y recabar datos sobre los tiempos de espera para recibir tratamientos de fertilización asistida. Entre las respuestas, si bien existían mujeres que habían esperado menos de un año, también se identificaron casos de espera de uno, dos, tres o hasta cinco años para poder realizar los procedimientos. Considerando las 66 respuestas, de las cuales 54 corresponden a libre elección y 12 a atención institucional, se puede desprender que, quienes se atienden con MLE —pagando los Bonos PAD— deben esperar en promedio un año y siete meses, mientras que quienes optan por la MAI y el copago cero, deben esperar dos años y siete meses en promedio. Aunque en cada caso el tiempo es distinto, la espera siempre es sinónimo de incertidumbre y ansiedad.
En marzo de 2022, y luego de sufrir tres abortos espontáneos, Roxana Vera (38), en ese entonces de 34 años y oriunda de la Isla Grande de Chiloé, decidió consultar con un especialista en Castro para identificar si existía algún problema con ella. Tras una serie de exámenes le diagnosticaron trombofilia, condición que hace que la sangre tenga una mayor tendencia a formar coágulos, lo que muchas veces genera pérdidas en el embarazo. Con el diagnóstico en mano y con el deseo latente de tener un hijo, Roxana decidió empezar con un tratamiento de fertilización asistida y ser madre soltera, sin embargo, el proceso no iba a ser tan fácil: “Me derivaron a Santiago porque acá en Chiloé obviamente no procesan todos los exámenes, no tenemos el mismo acceso que en la capital”, comenta.
En Chile existen únicamente 15 prestadores de Bono PAD para tratamientos de fertilización asistida y estos se encuentran concentrados en sólo cinco regiones: seis en la Región Metropolitana, cinco en Biobío, dos en Valparaíso, uno en Antofagasta y uno en La Araucanía, el cual sólo cuenta con tratamientos de baja complejidad. Las mujeres que viven en las 11 regiones restantes del país deben viajar para recibir los procedimientos necesarios, situación que no sólo requiere energía y dinero, sino también tiempo, que es un factor indispensable cuando se trata de tener un hijo.
Sin más preámbulos, en abril de ese mismo año, la chilota emprendió rumbo a la capital para hacerse los exámenes de chequeo, optando por el laboratorio del Hospital Clínico UC Christus, ubicado en la comuna de Santiago. El viaje lo hizo en bus desde Castro, tardando aproximadamente 18 horas tanto a la ida como a la vuelta, es decir, un total de 36 horas. Estuvo dos días en la capital, se hizo todos los exámenes correspondientes y volvió a la isla.
Imagen referencial.
Una vez analizados los resultados, y ya teniendo en consideración su deseo de ser madre, en julio el doctor de Chiloé la mandó nuevamente a Santiago para realizarse exámenes más específicos. Otra vez debía viajar, pero en esta ocasión decidió hacerlo en avión. Tomó un vuelo de dos horas con destino a la capital, de un costo de $80 mil ida y vuelta. Estuvo dos días allá y regresó. Afortunadamente, todos sus exámenes estaban en orden y en septiembre decidió comenzar el proceso para los tratamientos de fertilización asistida. Roxana empezó a atenderse en formato de telemedicina en la clínica de fertilidad CER, donde sus especialistas la controlaban de manera remota y la mandaban a hacerse exámenes y ecografías que afortunadamente podían llevarse a cabo en Castro.
El 15 de septiembre, Roxana comenzó el proceso para una inseminación artificial tomando medicamentos y haciendo un seguimiento ovular a través de ecografías día por medio. Sin embargo, cuando el óvulo ya se encontraba en un tamaño óptimo para la inseminación ya no había nada que pudiesen hacer en Chiloé: debía viajar una vez más a Santiago. El 28 de septiembre emprendió rumbo nuevamente a la capital, el 30 tuvo que ir a la clínica CER para prepararse y ponerse las inyecciones necesarias y, finalmente, el 1 de octubre le realizaron el procedimiento, para el cual tuvo que costear de su propio bolsillo una muestra de espermios de aproximadamente $400.000.
Afortunadamente, la inseminación dio el resultado esperado, y el 6 de junio de 2023 nació Mateo Emiliano. Sin embargo, para llegar a su preciado hijo, Roxana tuvo que viajar tres veces a la capital a realizarse todos los procesos requeridos —incluyendo 36 horas de viaje en bus y unas cuatro en avión— ya que, tanto en la Región de Los Lagos como en 10 regiones más del país, no existen centros médicos que ofrezcan tratamientos de fertilización asistida a través del sistema público. Esto deja en evidencia la desigualdad en el acceso a la salud reproductiva y la limitada cobertura que tienen estos procedimientos, lo que obliga a muchas mujeres a desplazarse largas distancias y asumir costos adicionales.
Cabe destacar que la chilota es la excepción a la regla, ya que según la revista médica acreditada “Reproducción Asistida ORG”, las tasas de éxito de inseminación artificial no son muy elevadas, sobre todo en el primer intento y por lo general se logran los resultados luego de dos, tres o más intentos.

Los casos de Jessica y Roxana no son aislados y, a pesar de que la infertilidad es reconocida por la OMS como una enfermedad, en Chile la legislación no está a la altura de ese reconocimiento. Aunque el presidente Gabriel Boric anunció en su Cuenta Pública en junio de 2025 un proyecto de ley para regular y facilitar la fertilización asistida, a la fecha aún no ha habido indicios de esta.
Dentro de la actual legislación se aborda en pocas ocasiones la fertilización asistida y se hace desde el área ética y legal de estos procedimientos, pero no considera aspectos como su cobertura, financiamiento o disponibilidad. Además, deja muchas preguntas sobre deberes, vínculos legales y derechos. El doctor Fernando Zegers comenta que “la defensa de formar familia con hijos es un derecho humano”, por lo que también, aquellas leyes o políticas públicas que se generan no deben ser solamente para combatir el problema demográfico actual, sino para garantizar este derecho.
La fundación Fënn ha sido una de las principales impulsoras de una ley integral de reproducción asistida en Chile. Sin embargo, no han podido avanzar: “No logramos que sea prioridad, porque la gente no ve la infertilidad como el problema que es”, revela la fundadora, Fiorella Squadritto. Entre sus propuestas está la creación de un Consejo Nacional de Reproducción Asistida para fiscalizar los procedimientos de fertilización a lo largo de todo el país, ya que, actualmente, si alguien tiene un problema con un centro de salud en el que se está haciendo un tratamiento de fertilidad, no hay una entidad especializada a la que acudir para reclamar.
Por otra parte, la senadora de Renovación Nacional, Paulina Núñez, ha levantado dos propuestas que buscan prevenir la infertilidad y educar sobre esta patología. La primera moción corresponde a un proyecto que intenta modificar el Código Sanitario con el fin de incorporar entre los servicios de los profesionales —como matronas y ginecólogos— la responsabilidad de entregar información sobre la temática en cuestión. El segundo proyecto busca modificar la Ley N° 20.418 para que el Estado cree políticas públicas que apoyen a las personas con infertilidad. Actualmente, esta ley regula la información y servicios sobre fertilidad e infertilidad. Si bien el proyecto de ley se encuentra en tramitación desde hace más de un año, está catalogado como “sin urgencia”.
Hoy, Jessica Durán mira a su hija Milagros con alivio y gratitud. Sabe que cada lágrima, cada espera sin respuesta y cada puerta cerrada finalmente valieron la pena. Por otra parte, cada kilómetro que recorrió Roxana Vera fue una apuesta cargada de esperanza que la llevó a alcanzar lo más valioso de su vida. Hoy, Mateo Emiliano —quien en junio cumple tres años— corre y salta por los rincones de Castro acompañado de la mano de su mamá, la cual, aunque tuviera el cuerpo cansado, siempre viajó con el corazón firme para llegar a él.
Este reportaje fue realizado por las estudiantes Isidora Prieto y Magdalena Soublette, en la sección de la profesora Paulette Desormeaux del curso Taller de Periodismo Avanzado de la Facultad de Comunicaciones de la Pontificia Universidad Católica de Chile.